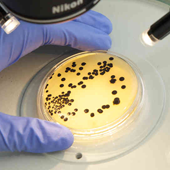

Tests and Facilities
Hematology

Hematology is the study of the morphology and physiology of blood. The haematology laboratory set in a healthcare setting is concerned with the diagnosis and monitoring of diseases of the blood and blood-forming organs. Biomedical scientists working in a haematology laboratory perform an array of blood tests that investigate the cellular elements blood and a number of proteins including haemoglobin and clotting factors. Haematological tests are performed on blood samples to diagnose diseases such as leukaemia, anaemia and abnormalities of blood coagulation.
Biochemistry
Biochemistry, sometimes called biological chemistry, is the study of chemical processes within and relating to living organisms. By controlling information flow through biochemical signaling and the flow of chemical energy through metabolism, biochemical processes give rise to the complexity of life.
Hormonal Assay

Many hormones can be measured (assayed) in the blood, to give an indication of metabolic processes and conditions, or “hormone imbalance”. These include male and female sex hormones (oestrogen, progesterone, testosterone) and hormones secreted by other glands such as parathyroid and adrenal glands.
Our Specialities
-
Quality
We assure quality controlled reports checked by expert professionals and clinicians.
Dependable
Friendly cordial staff for you and your family needs with Nice ambience.
-
Service
Quick and prompt service. Providing home collection facility on prior appointment.
Closer to you
Strategically located in the highway with ample parking facility and near to major residential area providing point of care patient outreach.
